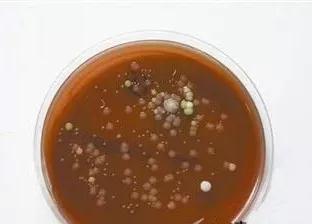

一说到喝水,小编就有一个疑问忍不住想问大家,不知道你们每天都是怎么喝水的,是长期喝饮水机里的水呢?还是习惯用水壶烧水喝?遥想当年,当小编还是个孩子的时候,家里是用这个烧水喝的。

后来进入到21世纪,第一次在家里见到饮水机。从此喝水变得好高级,随时都能喝到水。再也不必为热水瓶里的水太烫而发愁,也不用担心水快喝完了要赶快烧,要不然就没开水喝。
但是,这些年饮水机在方便了大家的同时,貌似问题也很多啊。
苏州姑苏区市场监督局检查人员在一家商铺内,对一台正常使用中的饮水机进行检测,结果表面清洁度严重超标!
经过检测,这台半年未清洗的饮水机,卫生指数竟超标1300倍!

这不,广州还有一位李女士,就因为「喝水」被送进了医院……
事件经过:李女士早上起床,喝了一杯从饮水机里接出的水,没过一会儿就开始腹痛难忍。去医院检查后,医生说她得了急性肠胃炎,初步判断是因为吃错了东西。
李女士觉得很奇怪,自己从早上到现在只喝了一杯水而已,并没有吃其他东西。
出院后,李女士检查了饮水机,打开了很久没有清洗的饮水机内部,看到了让人头皮发麻的一幕:

饮水机里居然有小强!!!
而且像这种脏到不忍直视的饮水机,并不是个例!

饮水机容易成为清洁盲点
饮水机的内部属于一个半封闭的环境,我们平时很少注意到里面的卫生情况,容易忽视饮水机的清洁,产生健康隐患。
据有关国家环境卫生监测部门检测显示,桶装饮水机内的冷热水胆3个月不洗就会大量繁殖细菌和病毒!包括大肠菌群、粪链球菌、双歧杆菌属、肠道病毒、大肠杆菌噬菌体、沙门氏菌属、葡萄球菌属、副溶血弧菌等等等。
数量有多少?说出来吓死你!每毫升水里能有10万以上的细菌!不只是能开大会还来个大轰趴~长期喝有这些家伙的水可能引发消化、泌尿、神经系统疾病。
还能养出虫儿

除此之外,有些小虫子也可能来凑个热闹,比如红线虫、孽生红虫,这些都能在长期不清洁的饮水机中滋生。你说恶不恶心?
